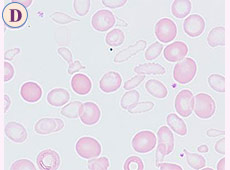

前 略
夢にまでみた郷里での“兄弟3人展”は、2月22日(日)~3月21日(土)に大分県杵築市山香郵便局の美術室で開催され無事終了しました。
期間中は多くの方々がお越し下さり励ましの言葉やお志を、また遠方より華麗なお花を沢山頂きありがとうございました。素人展にも拘わらずこんなにも沢山の暖かいお気持ちを頂きましたことに改めて感謝申し上げます。
そして、ご推薦頂いた山香郵便局長さんには隅から隅までご配慮下さいましたことに厚くお礼申し上げます。
長男(英旭)は南画を5点、次男(漣 連十郎)は油絵を7点、三男の私(麗旭)は美人画を19点展示致しました。
長男は南画の師範をもち指導という立場、次男は県美展に4回当選するまでの腕前、私はというと全くの素人画法でしたので心配しておりましたが、美人画ということが珍しかったのか、少しは救われた感がありました。
地元の新聞社からも取材を頂き“美人画のどこをみてもらいたいですか?”の問いに、特に毛先、顔の輪郭、目の描写などをあげ、何よりも着物の絵柄の難しさをお伝えしました。
記者さんからは、“親子展はあっても兄弟3人展は珍しい”とのことで、今回の企画は間違っていなかったと少し自負しております。そして何よりも“兄弟の固い絆” がさらに強くなったことを感じております。
3人とも高齢ですが至って元気ですので、親から譲り受けた健康な身体に感謝しながらこれからも創作活動を続けていきたいと思っております。
東北大震災(2011.3.11)から今年で4年を迎えましたが、震災の年の7月23日に開催が危ぶまれた東北地区血液研修会(仙台)が東北の皆様の強い要望によって開催された時、ご当地の皆様から“生きる強さ”を頂いたことが忘れられません。その時、“負けないで東北復興と創生に 願いを込めて”の文言を美人画に託し参加された150余名の皆様にお配りさせて頂いたことがあります。不幸にして2名の知人を亡くしましたが、それ以来、毎年元旦には3点ほどの美人画を描くように心がけています。
犠牲者の皆様や亡き友を偲ぶとともにまだ不自由な生活を余儀なくされている皆様の復興を願って‥‥。
草々
形態マガジン号キャプテン 阿南 建一 

大分合同新聞.2015.3.13

長男の作品(南画)

次男の作品(油絵)

私の作品(水彩画)

展覧会場
今回は末梢血における先天性異常と貧血症、骨髄における形態診断に挑戦します。
末梢血では、白血球の形態異常として稀な先天性異常を提示しました。
また、よく類似した赤血球の形態異常を呈する貧血症を提示しました。
骨髄では、PO染色陰性の急性白血病を提示しました。
これらのなかには特徴的な形態像を示すものもありますので、形態像から診断を進めながら、確定診断のための所見も考えてみて下さい。
末梢血のA~DのMG染色から考えられる疾患をリストより選んで下さい。



PB-MG×1000

骨髄のA~DのMG染色から考えられる疾患をリストより選んで下さい。これらは、PO染色陰性の急性白血病ですが、確定診断への所見も考えて下さい。



BM-MG×1000

問題 1
(正解と解説)
先天性異常にみられる白血球の形態異常と類似した赤血球形態を呈する疾患です。
【正解】
(CASE A) ④.Chediak-Higashi異常症
(CASE B) ③.Jordan異常症 (CASE C) ⑧.鉄欠乏性貧血
(CASE D) ⑦.鉄芽球性貧血
【解説】

問題 2
(正解と解説)
ここに提示した急性白血病はいずれもPO染色に陰性のAMLです。CaseB.とD.は形態学的特徴を示すものと思われますが、CaseA.とC.は悩ませる例かも知れません。
【正解】
(CASE A) ②.M0(最未分化型急性白血病)
(CASE B) ⑦.M5a(低分化型急性単球性白血病)
(CASE C) ⑧.M6b(未分化型赤白血病)
(CASE D) ⑨.M7(急性巨核球性白血病)
【解説】




これから先のページでは、医療関係者の方々を対象に医療機器・体外診断薬等の製品に関する情報を提供しております。当社製品を適正に使用していただくことを目的としており、一部の情報では専門的な用語を使用しております。
一般の方への情報提供を目的としたものではありませんので、ご了承ください。
医療関係者の方は、次のページへお進みください。
(お手数ですが、「進む」ボタンのクリックをお願いします)